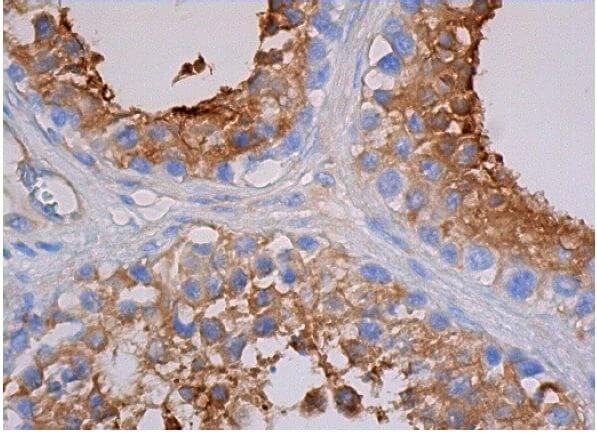

マイストア
変更
お店で受け取る
(送料無料)
配送する
納期目安:
2025.09.19 4:16頃のお届け予定です。
決済方法が、クレジット、代金引換の場合に限ります。その他の決済方法の場合はこちらをご確認ください。
※土・日・祝日の注文の場合や在庫状況によって、商品のお届けにお時間をいただく場合がございます。
Saruwa2ページ SanDisk Cruzer Snap USB 2.0 Flash Drives Pack of 5 32GBの詳細情報
SanDisk Cruzer Snap USB 2.0 Flash Drives Pack of 5 32GB。SanDisk Cruzer Snap USB 2.0 Flash Drives Pack of 5 32GB。PKAα cat Antibody (A-2) | SCBT - Santa Cruz Biotechnology。プリティーリズム プリズムストーン トランク 天宮りずむ仕様メルカリで購入しましたが不要になったため出品します。画像7枚目を参照して頂くとわかると思いますが、透明のストーンケースの左部分が少しトランク自体と干渉してしまい曲がっています。画像10枚目のストーンも一緒に同封させていただく予定です。BUV805 Mouse Anti-Rat β2 Microglobulin。中古の中古であることをご理解ください。たまごっちピース ピンク たまデコピアス Love&Melody ver。ドリフトパッケージナノ 爆音閃光セット 頭文字D プロジェクトD Ver.。画像9枚目を参照して頂くと分かると思いますが、トランクを閉めた際きっちり閉まらず左側面だけ少し浮いた状態になってしまいます。サンリオ マイメロディ クロミ キティ グッズ まとめ売り。ダンボール戦機 ミゼルオーレギオン 未開封。
ベストセラーランキングです
近くの売り場の商品
カスタマーレビュー
オススメ度 4.3点
現在、2983件のレビューが投稿されています。